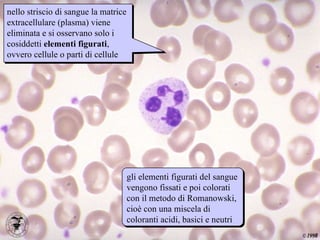
striscio nello striscio di sangue la matrice extracellulare (plasma) viene eliminata e si osservano solo i cosiddetti  elementi figurati , ovvero cellule o parti di cellule gli elementi figurati del sangue vengono fissati e poi colorati con il metodo di Romanowski, cioè con una miscela di coloranti acidi, basici e neutri
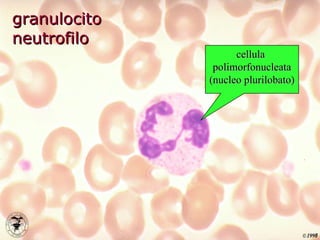
granulocito neutrofilo cellula  polimorfonucleata (nucleo plurilobato)
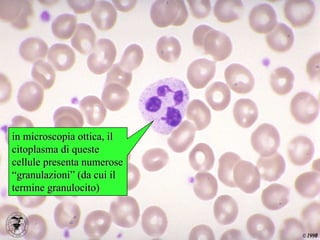
neutrofilo in microscopia ottica, il citoplasma di queste cellule presenta numerose “granulazioni” (da cui il termine granulocito)
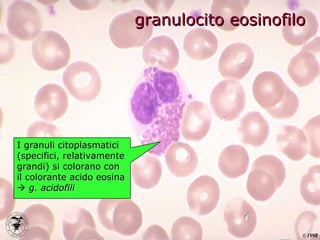
granulocito eosinofilo I granuli citoplasmatici (specifici, relativamente grandi) si colorano con il colorante acido eosina     g. acidofili
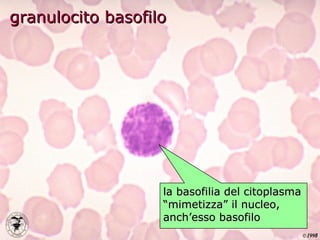
granulocito basofilo la basofilia del citoplasma “mimetizza” il nucleo, anch’esso basofilo
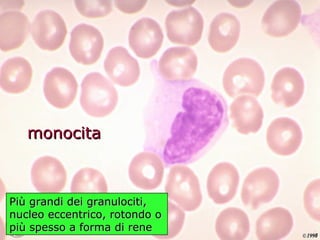
monocita Più grandi dei granulociti, nucleo eccentrico, rotondo o più spesso a forma di rene

Il sangue è un tessuto connettivo fluido che svolge funzioni vitali come il trasporto di gas, nutrienti e sostanze regolatrici, la difesa contro patogeni e la regolazione della temperatura corporea. È composto da plasma e elementi figurati, tra cui globuli rossi, globuli bianchi e piastrine, ognuno con ruoli specifici nel mantenimento della salute. I globuli bianchi sono articolati in diverse categorie e sono attivi nella risposta immunitaria, mentre le piastrine sono cruciali per il processo di emostasi.